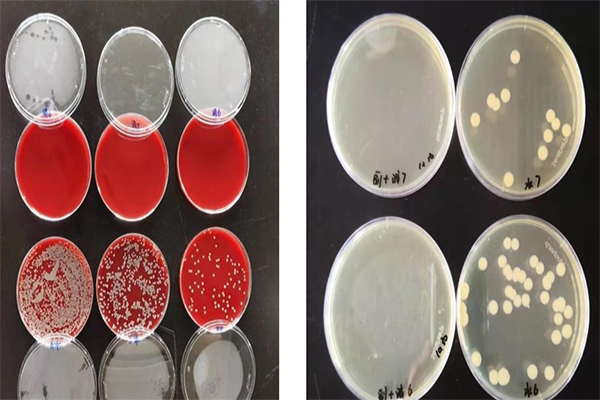
非洲豬瘟如何消毒防控 非洲豬瘟如何消毒防控

非洲豬瘟如何消毒防控
近幾年來,我國多地爆發(fā)非洲豬瘟。導致豬肉價格飛漲,即便是到今天為止,非洲豬瘟仍然是我國養(yǎng)豬業(yè)最大風險和威脅之一。
非洲豬瘟發(fā)病特征
發(fā)病期一般在3一5天左右,生豬開始出現(xiàn)厭食,體溫逐漸增高,懶惰四肢無力,皮膚出現(xiàn)小型紅紫色斑塊。隨著病情的加重發(fā)紺部位逐漸擴大,體溫持續(xù)到40度以上,然后進入死亡期,死亡前期生豬體溫下降是其和其它疫情最大的區(qū)別。
截止到目前為止,還沒有特別有效的非洲豬瘟治愈手段,所以在非洲豬瘟防治方面,還是以預防為主:做好各環(huán)節(jié)消毒工作。
傳統(tǒng)消毒手段存在的不足
成本高昂
以100頭母豬規(guī)格為例,引種就要接近50萬,防疫設備基本也要50萬,總共要100萬,這個投入還是在現(xiàn)有的場地的基礎上的投入。那種沒有防疫投入的散養(yǎng)戶染病是早晚的事。
平常的防疫費用只要體現(xiàn)在:每周的消毒水要900塊,然后還要專門配置一個人進行消毒,人工費一天120,一個月就要接近8000的投入
對環(huán)境破壞嚴重
l對環(huán)境不友好,有殘留。一些消毒藥如甲醛、戊二醛、苯酚、燒堿
等對環(huán)境破壞嚴重,成噸成噸的消毒藥被投入到環(huán)境中、水體中,造成
巨大的環(huán)境污染。
l糞污不能發(fā)酵,形成二次污染。
l對人畜毒副作用大,刺激味重。如醛類、酚類、強堿性消毒劑,不
能帶畜消毒。
布網(wǎng)式豬場消毒方案
在豬場出入口、人豬走道、圈舍門口、豬圈、出豬臺、飲水池、沖圈水池等可以傳播疾病地方布下消毒管道,每天定點、定量,加機動進行噴霧和灌注消毒,對空氣、圈舍、地表、豬體表、用水全面消毒。
?
采用可生產(chǎn)微酸性次氯酸消毒水的設備

微酸性次氯酸消毒水特點:
1.成本低:原料只有水和食鹽,每噸綜合成本十幾元。
2.無毒副作用、無殘留:作用后主要產(chǎn)生物為水和微量食鹽。
3.應用場景廣泛:人車出入口、出豬臺、走道、圈舍、環(huán)境、飲水、沖圈水、空氣、用具、動物體表等。可做到豬場全環(huán)境消毒。可更有效的預防疾病傳染病的發(fā)生。
4.方案靈活:可根據(jù)豬場實際情況設定自動環(huán)節(jié),也可根據(jù)實際需求進行手工消毒。
殺菌效果、使用效果
? ? ? ? ? ? ? ?對豬鏈球菌和副豬嗜血桿菌的殺滅作用

? ? ? ? ? ? ? ? ? ? ? ? ? ? ? ? ? ??對大腸桿菌和金黃色葡萄球菌的殺滅作用
? ? ? ? ? ? ? ? ? ? ? ? ? ? ? ? ? ? ? ? ? ? ? ? 細菌病毒殺滅試驗匯總
